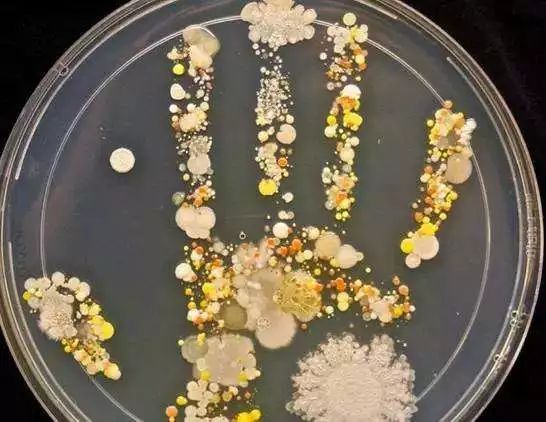

|
网红饮料比刷锅水还脏?知道真相后再也不想喝了科普中国微平台 2018-05-07 |
本文专家:刘静,华东理工大学食品质量与安全方向研究生
本文审稿:刘少伟,华东理工大学食品药品监管研究中心副主任、教授,美国宾夕法尼亚州立大学食品科学博士,美国堪萨斯州立大学博士后
网红饮品店已在很多城市火了起来,一杯奶茶排队一小时、一个水果杯排队半小时……这些听起来似乎不可思议的事情,现在却正在各地上演。
近日,北京电视台记者卧底某饮品店,发现“新鲜”饮品内幕,其真相令人震惊!店员直接用手在挤茶包里的汁液,连她自己都直呼恶心,但仍将茶包里的汁液挤到杯子里备用!
店里也摆放了很多新鲜的水果,其中芒果看起来十分诱人。但这仅仅是作为摆设,真正用来榨汁的却是发黑的芒果!店员将发黑的地方剔除,剩下的用来榨汁!

记者还发现,很多当天没有卖出去的饮品、切好的水果杯会被放进冰箱,第二天再拿出来“二次销售”。当我们看到桌面上琳琅满目的“鲜果杯”时,并不知道自己购买的那一杯,会不会是刚从冰箱里拿出来的“隔夜货”。

那么,不带手套直接用手做的饮料,到底有多脏?水果把霉变部分切掉还能不能吃?今天就为大家科普一下网红饮料存在的安全隐患问题!
隐患一:不带手套直接用手做饮料,到底有多脏?
日常生活中,我们的手直接、频繁地接触物品,手部皮肤上带有细菌、病毒等各种微生物,其中以皮肤褶皱和指尖上最多。科学实验证明,一双未洗过的手上最多有80万个细菌,而仅仅微乎其微的一克指甲垢里就藏有38亿个细菌。
这些细菌不仅有可能使人体染上病,还可能通过握手、接触其它物品(如食物)等方式,把这些细菌传播给别人。不洗手就接触食物,会使细菌和病毒经口进入体内,对健康造成威胁。
隐患二:水果发霉部分切掉,剩下的还能继续吃吗?
霉菌感染变质的水果绝对不能吃!水果放久了,会慢慢腐烂,开始长霉菌,而霉菌容易渗透,会扩散到水果的其他部位,导致整个水果都受到霉菌的污染。所以霉变了的“坏”水果,请立即丢进垃圾桶!
隐患三:未卖出的水果杯放冰箱再进行“二次销售”安全吗?
切开的水果,放在冰箱的冷藏室里最多不要超过12小时。当然,越快吃完越好。水果表皮易受污染物、化学物品、动物排泄或沙门氏菌等细菌污染。
假如新鲜水果没有经消毒处理,水果表面可能有沙门氏菌类。而用刀切开没有经过清洗的新鲜水果时,受污染的蔬果外皮的细菌会经过刀传给食用部分。切开的水果在室温下存放太久,细菌便会滋生。
现在网红饮品越来越多,商家利用年轻人的猎奇心理打造网红品牌,但这样往往会导致商家过分追求“网红效应”,而忽略了背后的食品安全。
有时候,网友们对购买量、信誉度较高的店铺往往较为信任,可能会对产品的安全性、合规性有所疏忽。
然而,食品安全与其他产品不同,一旦我们食用了不合规范的食品,对身体带来的伤害是难以估量的。
食品安全问题频发的今天,网红店一次次被曝出“丑闻”,热衷于追求“网红”饮料的消费者,也是该吃一堑长一智了。
责任编辑:王超
科普中国APP
科普中国微信
科普中国微博

最新文章
-
为何太阳系所有行星都在同一平面上旋转?
新浪科技 2021-09-29
-
我国学者揭示早期宇宙星际间重元素起源之谜
中国科学报 2021-09-29
-
比“胖五”更能扛!我国新一代载人运载火箭要来了
科技日报 2021-09-29
-
5G演进已开始,6G研究正进行
光明日报 2021-09-28
-
“早期暗能量”或让宇宙年轻10亿岁
科技日报 2021-09-28
-
5G、大数据、人工智能,看看现代交通的创新元素
新华网 2021-09-28








